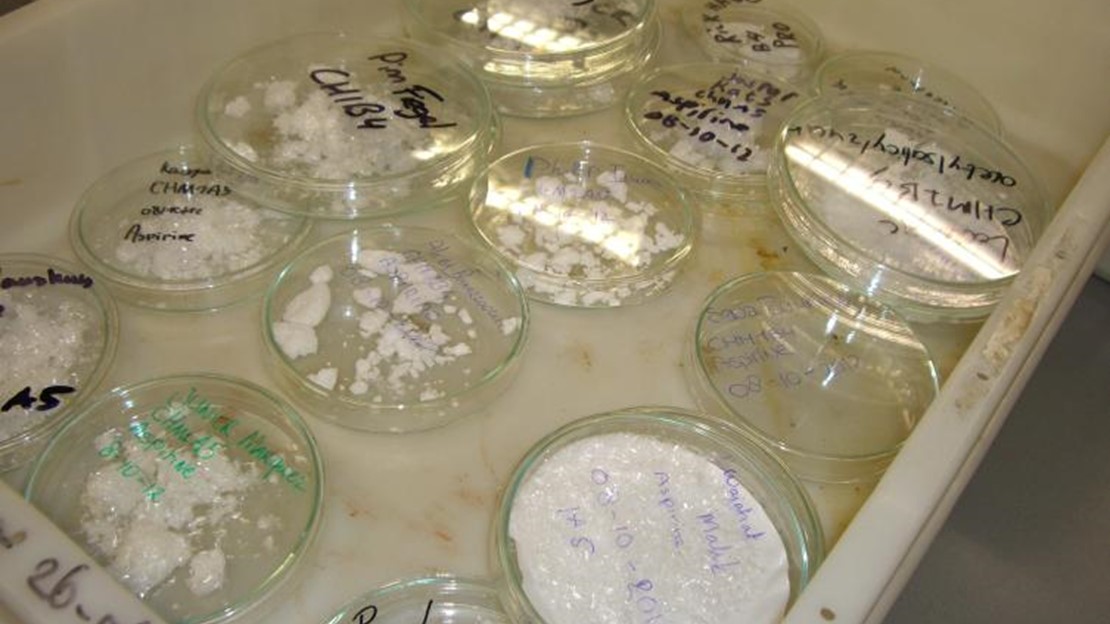

Vraagstelling
In opdracht van de opleiding Chemie zijn eerstejaars studenten aan de slag gegaan met de volgende casus. Een farmaceutisch bedrijf gebruikt Engelstalige recepten voor het maken van pijnstillers. Het personeel heeft echter moeite met het vertalen en omrekenen van deze recepten. Vraag: kunnen de recepten worden vertaald en omgezet in bruikbare synthesevoorschriften voor het veilig en efficiënt bereiden van pijnstillers?
Aanpak
De eerstejaars studenten Chemie vertalen de Engelstalige recepten naar het Nederlands en zetten ze om naar synthesevoorschriften. Om hun eigen voorschriften in de prakijk te testen, voeren ze in het laboratorium de synthese van een aantal pijnstillers uit, en analyseren ze het resultaat.
Resultaat
De Engelstalige voorschriften zijn vertaald, omgerekend en omgezet in synthesevoorschriften. Alle studenten hebben vervolgens zelf aspirine en paracetamol gesynthetiseerd en geanalyseerd. De voorschriften bleken goed uitvoerbaar en de aspirine en paracetamol bleken van goede kwaliteit.
Opleiding(en)
- Chemie
Type
Project
Begeleider(s)
V.O.M. Beke, J. Berding, K. El Azzouti, C.B. Minkenberg